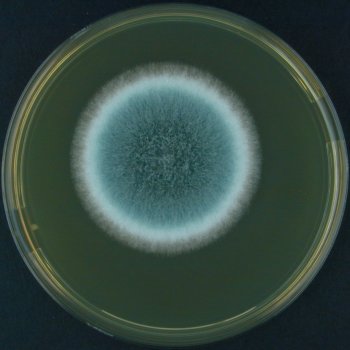

El Objetivo principal de una empresa de desinfección es prevenir las enfermedades infecciosas en los sectores higiénico-sanitarios, alimentarios, hoteleros, etc...
Los métodos de prevención, protección y eliminación desarrollados por LB DESINFECCIONES MADRID,S.L. eliminan los agentes
patógenos (bacterias, virus y hongos) mediante un proceso físico o químico, impidiendo el crecimiento de microorganismos patógenos
en los hospitales, restaurantes u otras instalaciones.
LB DESINFECCIONES MADRID,S.L., empresa de desinfección y control de plagas, ante ambientes que pueden generar un determinado
riesgo para la salud debido a la presencia de microorganismos patógenos, realiza una analítica microbiológica previa que estima el
número de unidades y especie de colonias, para posteriormente escoger el método de desinfección adecuado. Y es que la limpieza y
desinfección son aspectos necesarios para preservar Salud Pública.
En LB DESINFECCIONES MADRID,S.L., ofrecemos un completo servicio de desinfección de ámbito doméstico y profesional.
Entre los microorganismos mas importantes se encuentran:
- Aspergillus fumigatus
- Salmonella
|
El Aspergillus es un género de alrededor de 200 hongos (mohos), y es ubicuo. Los hongos se pueden clasificar en dos formas morfológicas básicas: las levaduras y las hifas. El Aspergillus es un hongo filamentoso (compuesto de cadenas de células, llamadas hifas), el tipo de hongos opuesto a las levaduras, éstas últimas compuestas de una sola célula redondeada. El hábitat natural del Aspergillus son el heno y el compostaje.
| |
|
La Salmonella es un género de bacterias que pertenece a la Familia Enterobacteriaceae, formado por bacilos gramnegativos, anaerobios facultativos, con flagelos perítricos y que no desarrollan cápsula (excepto la especie S. typhi ) ni esporas. Son bacterias móviles que producen sulfuro de hidrógeno. Fermentan glucosa por poseer una enzima especializada, pero no lactosa, y no producen ureasa.
|    |





